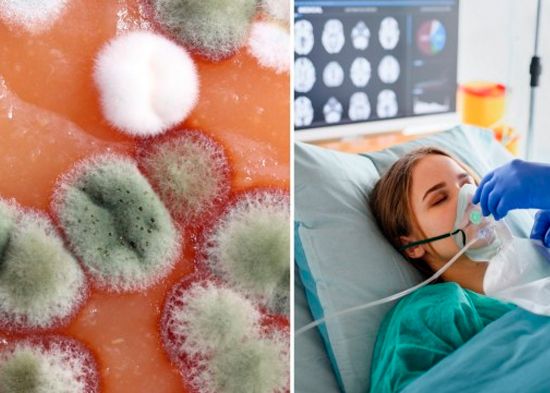

¿Qué es la Candida auris? El hongo resistente a fármacos que se puede encontrar en hospitales
En los hospitales hay una frase, que si has sido paciente seguro llegaste a escuchar. “Estás más seguro en casa”, y es que hay microorganismos capaces de resistir cualquier medida de higiene y pueden llegar a ser potencialmente mortales.
¿Qué es la Candida auris?
Es un hongo emergente unicelular que tiene un alto grado de resistencia a los tres tipos de tratamientos antimicóticos disponibles, y que se encuentra diseminado en los servicios de salud, describe la Organización Panamericana de la Salud.

¿Qué es la Candida auris? El hongo resistente a fármacos que se puede encontrar en hospitales
¿Dolor de cabeza y articulaciones? 5 síntomas de hongos en los pulmones
Qué puede causar este hongo en tu cuerpo…
De acuerdo a los Centros para el Control y la Prevención de Enfermedades, el hongo de la Candida auris puede causar:
1-Infecciones invasivas sanguíneas y de otros tipos.
2-Se está volviendo más frecuente. Si bien este hongo se descubrió a penas en el 2009, a partir de entonces el número de casos reportados va en aumento.
3-Es difícil de identificar. Es necesita de métodos especializados de laboratorio, y entre más rápido mejor, ya que se pueden iniciar las medidas para detener su propagación.
4-Puede propagarse y causar brotes. Coloniza a pacientes por muchos meses, perdura en el ambiente y resiste algunos desinfectantes.
Síntomas de una infección por Candida auris
Es posible que no se noten, en especial si el paciente ha sido hospitalizado por otras afecciones. Sin embargo, algunas de las señales son similares a una infección del torrente sanguíneo o por herida.
1-Escalofríos
2-Confusión o delirio
3-Fiebre o temperatura
4-Mareo y debilidad
5-Latidos cardíacos rápido
6-Erupción cutáneas o piel moteada
7-Piel caliente
No obstante, para poder saber que se trata de este hongo es necesario estudios de laboratorio.
¿Quién tiene más probabilidad de contraer una infección por Candida auris?
1- Principalmente pacientes que tienen muchos problemas médicos.
2- Personas que han estado hospitalizadas por largos periodos
3- Suele afectar a personas con un sistema inmunitario débil por alguna enfermedad, como algún tipo de cáncer o diabetes.
Las personas sanas no suelen enfrentarse a este tipo de infecciones. Por otro lado, esta afección es tratable con medicamentos llamados aquinocandinas. Aunque, los centros de salud tienen que hacer pruebas de rutina para detectar este hongo, si tú como paciente te recomiendan pasar la recuperación en casa. ¡Créeles es mejor!